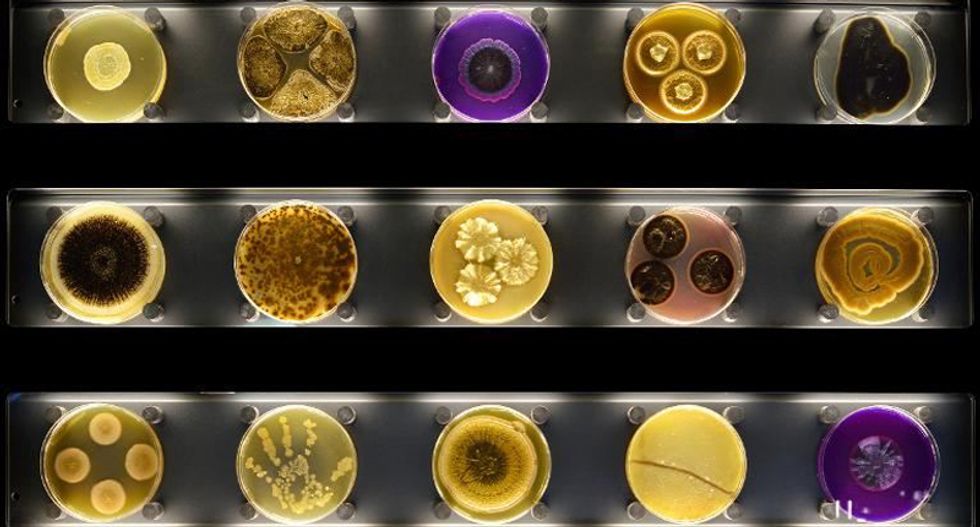

In this undated photo released by Micropia on September 30, 2014, Petri dishes are displayed with microbes growing in them, on display at Amsterdam's Micropia museum (AFP)
In us, on us and all around us. Microbes image via www.shutterstock.com. Most of us considered microbes little more than nasty germs before science recently began turning our view of the microbial world on its head. A “microbe” is a bacterium and any other organism too small to see with the naked eye. After decades of…




